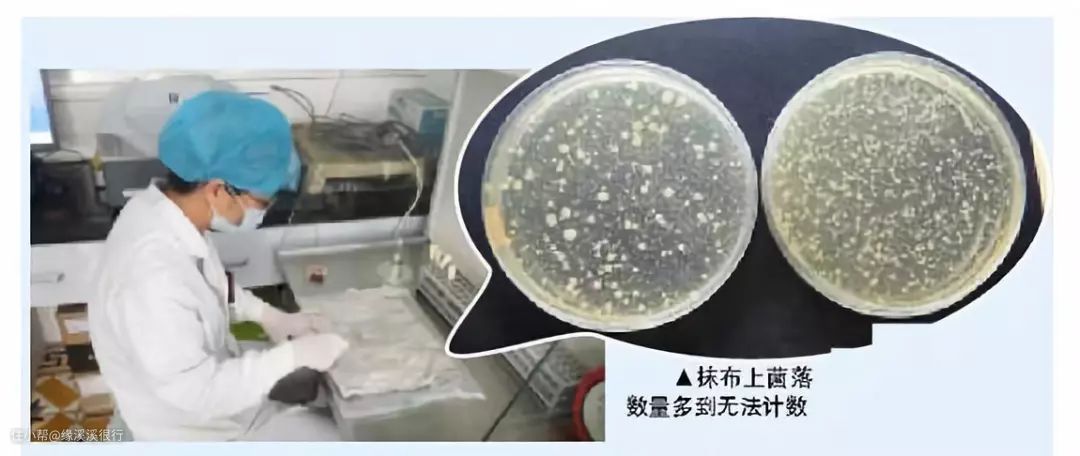

打扫三室两厅耗时一时三刻,盘点那些好用的春节大扫除工具
缘溪溪很行
2021-02-22
写在前面的话
过年意味着什么?
对于很多人来说,过年可能意味着收好多好多的红包。也可能意味着吃好多好多的好吃的,还有可能是连躺七天各种追剧游戏……
醒醒吧!在享受过年的幸福假期之前,你们是不是忘了什么?

在我看来,为什么一个好好的春节假期,要变成了“劳动节”?我爹形容我妈的一句话,时隔多年仍然让我心有余悸:“你妈是逮不着耗子,要不然春节前也要给它们秃噜秃噜毛,干干净净的过年!”
虽然大扫除过后的窗明几净让我们确实觉得万象更新,但是大扫除的过程实在苦不堪言。在只有一双手、一盆水、一块抹布、一个刷子的年代,大概过年前的全家大扫除,是除了过年给不熟悉的亲戚拜年或者被不想理的亲朋催婚问收入问成绩之外,让我最讨厌的事情了!
不过进入21世纪都已经21年了,打扫卫生这件事,早已充满了科技感。在满家“君子动口不动手”的智能家电环绕中,怎么可能还是一双手一盆水呢?这诸多的清洁好物难道都是吃干饭的么?
一般来说,家里大扫除的内容不外乎几个方面:清扫尘土,擦玻璃,擦地,最后将家里的窗帘被罩床单瓶瓶罐罐都洗一遍。
一、吸尘:
一般我都是先从吸尘做起,因为边吸地,就开始边收拾满家散落的物品,归整好后至少看起来有了干净整齐的雏形了。
1、追觅T20吸尘器
很多人日常的除尘工作,基本都是交给扫地机器人来做的,但是年底大扫除的意义不就在于给耗子秃噜毛么?所以必须要手持吸尘器认认真真的边边角角的好好吸吸。

▲家里的戴森服役多年,最近实在年老体迈,濒临退休了,于是在年前入手了这款追觅T20吸尘器。

▲以前用戴森总是纠结在到底选最大吸力还是普通吸力上,因为吸力大续航就短,不够打扫完整个家,但是吸力小又总觉得不干净不够劲儿。而换了追觅T20后,最棒的体验就是,吸力大,续航足,就算手再慢,吸的再仔细,70分钟超长续航总够用了吧?

▲什么?你家是别墅?不够用?好,追觅T20吸尘器可以更换电池,再来一块,总够了吧?

▲几款配件也比较实用,基本可以涵盖整个家庭清洁的方方面面了。地面滚刷应对普通家庭木地板、瓷砖,甚至地毯都足够了,吸力大,细屑、毛发、食物残渣都可以轻松吸起。

▲除螨吸头可以对针织物表面进行深层清洁,尤其是天天都要躺的床铺、沙发等,更是要彻底过几遍。

▲过年大扫除就是要针对平时不怎么管的角落下手,比如这些缝隙、夹缝中的陈年尘土,用追觅配套的软管和缝隙扁刷都可以清洁到位。

▲当然,对于高处来说,也别拿身高当借口,因为追觅T20吸尘器的人体工学设计,可以让你轻松举起,就算天花板的蜘蛛网也可以吸的干干净净。

▲当然,追觅T20吸尘器是吸拖一体的,可以外接磁吸水箱,边吸边拖地,但是我个人更倾向于用喷雾拖把。
▲尘盒满了后,一按即可倾倒,不会造成二次污染,而且里面的尘杯、滤芯,甚至滚刷都可以拆卸下来用水清洗,既保持了干净,又可以重复利用减少损耗。
2、追觅慧目F9吸拖一体机
扫地机器人是日常清洁主力,吸尘器是周期清洁主力,两个缺一不可。尤其是过年前刚打扫干净的家,可不能毁于一旦啊,必须靠扫地机器人来保持啊,天天走一遍。

▲推荐大家买扫地机器人的时候一定要搞个超薄的,这样基本家具家电下面都可以通过,清扫起来就更彻底更干净了。追觅RVS5扫地机器人8cm的超薄机身高度,基本在我家里无所阻挡,所有的柜子都可以进去,这样基本就没有了卫生死角,家里可以被清扫的干干净净。

▲打开上盖,可以看到集尘盒,集尘盒的容量足有600ml,在一千元机型中,基本属于最大的,和两千元机型的石头T7和360x95对标,足够好好的清洁一次普通150平米的住宅了。
▲追觅RVS5扫拖一体机的2500Pa大吸力,别说应对日常清洁,即使是我们天天开窗就进土的北方,每天也可以保持家里的清洁。
▲过年期间家里最常见的垃圾就是食物碎屑,尤其是在餐厨房,或者客厅,比如熊孩子吃掉地上的薯片残渣,或者各种饼干屑。食物残渣又细碎又黏连,很不容易清理,这次我用一些饼干碎屑和米饭粒来模拟,可以看得出,随着追觅扫地机器人走过,饭渣基本都被清理干净。当然如果已经被粘在地面上的话,清理起来可能还是有一点困难的,不过想想一旦拥有了扫地机器人,那必须是一天最少一次的清净频率咯,怎么会让污渍过夜?

▲最后看看清扫了好几次的集尘盒,这大概是我使用三四次后,可以看得出,集尘盒都还没有满。600ml,大容量,在这时候体现出了充分的优越感。
3、宝家洁静电除尘掸
虽然吸尘器有刷头可以吸桌面,但是总感觉还是不如掸子擦一遍来得干净。当然,每个八零后心里都有一根鸡毛掸子,一头用来除尘,一头用来打屁股。只是现在基本已经没有人家里有鸡毛掸子了,毕竟一边掸尘,一边制造二次污染,所以早就被淘汰了。现在我们用的都是静电除尘掸啦,一擦而净,更方便更干净。

▲厚实的纤维毛,靠静电吸附尘土,掸尘的时候不扬尘,不会造成二次污染。

▲长短可调,最长可以接到4米,就算是天花板也毫无压力。

▲掸头可以随意弯曲,对于缝隙拐角处也可以伸进进行深层清洁。

▲而且很方便的可以进行水洗清洁,反复使用,性价比比较高。
二、擦玻璃
有没有人和我一样,这辈子最痛恨的两项家务就是:擦玻璃和洗碗!
为了避免洗碗,我换了洗碗机,而为了不擦玻璃,我一直都是雇人擦的,反正平时都有纱帘也看不见,而且擦一次三百块,管半年,基本还可以接受。直到今年疫情后,不太方便让别人进家来擦玻璃了,而且58上擦玻璃全面涨价!洗纱窗还要加钱!
1、玻妞擦窗器
所以第一时间速度入手了玻妞擦窗器,也算半自动的解放了自己擦玻璃这件事。当然相比较雇人擦玻璃,用玻妞擦窗器当然还是有一定弊端的,比如,还需要我给它充电,倒水,洗布子,哈哈,但是优点就是一次投入,终身享受,不仅可以擦我家,还可以擦妈妈家,奶奶家,亲戚家,朋友家,甚至还可以租赁啊,天哪,说不定一个月回本了。

▲擦窗器这东西,年轻人是马上就可以接受,老年人可能要慢点,但是看着如此小巧,使用如此简单的擦窗器,而且不用因为心疼钱,一年就擦那么两三次,还要担心人家服务人员会不会掉下去,算不算我们的责任这种事情,估计马上也就能接受了。

▲和以前那种“好哥俩”式的擦窗器不同的是,玻妞是单面擦窗,干擦湿擦都可以。而且还可以手机控制,随时提醒你工作进度,就算电量用完了,也可以继续吸在窗户上半个小时,足够你去人工操作。

▲得益于这两块厚实的抹布和精准的路线规划,玻妞擦出来的窗户还是可圈可点的。当然,所有能让我不用动手而完成的工作,我对他们的容忍度都特别高!
2、鱼鳞抹布
以前小时候家里的抹布都是用了很久的毛巾或者旧衣服剪的,妈妈们总是觉得反正都是抹布,都是擦脏的东西,要那么好的材质干嘛。但是实际上我们都知道,抹布可能比我们想象的要脏得多,而且很多材质的布料并不适合做抹布,掉毛严重,不吸水,对于一些污渍完全没有办法清理干净。
▲想想用这样的抹布,到底是在制造污染,还是在清洁卫生啊。

▲所以我推荐使用这种鱼鳞抹布,特点就是速干、无痕、不掉毛,尤其是对于不锈钢、玻璃这种光洁表面特别适合。
▲比如擦水龙头,基本无需额外的清洁剂就能让表面闪闪发亮。
▲用来擦家具表面也是很不错的,不掉毛,如果用掺有柔顺剂的水清洗布子再擦过表面后,甚至还不容易吸附尘土,家具表面也能更长久的保持干净。
三、擦地
1、宝家洁免手洗喷雾拖把
一般来说,擦地都是放在大扫除尾声做的,以前那种布条拖把,吸满水后,以我的力气,是完全拿不动的,尤其是拧干的动作,我更使不上劲。所以后来,等拖把可以更新换代成什么海绵的、滚筒的、垫布的,我都愿意尝试一下。更甚者,irobot的电动拖地机和洒哇地咔的蒸汽拖把以及小田的蒸汽拖把我都入手过,但是大浪淘沙后,唯一回购且使用至今的是这款喷雾免洗拖把。

▲宝家洁这款喷雾免洗拖把,简直是集各种懒人要求于一身了。

▲底部灌水,省的插拔,肯定不会坏,140+平米的家么,注水两次就够了。
▲拖把头很灵活,基本所有的边边角角都可以很方便的擦到。擦过的地面也超级干净,最关键,很省力气啊,无需大力,地面清洁!傻瓜式操作,老公别喊不会,媳妇别喊没劲儿。
▲清洗的时候无需接触拖布,也不需要手套,一擦一刮就可以清洗干净了。当然为了倒脏水的时候不堵马桶,我从来都是先用上一代的小刮刀先把拖布上附着的脏物刮下来,再清洗,这样我感觉更好一点。

▲洗干净后,收起来直立在墙角就可以了,也不占地方,很快就可以干了,也不怕湿哒哒的发霉。水桶平时可以用来接水什么的,也蛮方便。悄悄说一句,我这个小气鬼,从来都是用桶在浴室接洗澡时最开始的那股冷水,然后正好用来擦地,会过日子的人美滋滋啊。
四、清洗
1、博世洗烘套装
除尘吸地擦地过后,就开始了清洗工作。而大扫除中的清洗工作包罗万象,从纱帘窗帘,到床单被罩,从沙发垫子,到各种罩子,妈妈们把所有能洗的都要洗一遍才罢休,但面临的一个问题就是,没有那么多地方用来晾晒啊。

▲反正我家的阳台,不可能晾晒衣物,这辈子都不可能,我要在阳台上种花,喝茶,跑步,反正就是不想晾晒衣物!

▲所以入手了博世的洗烘套装,这边洗,那边烘干,烘干就直接又铺挂了回去,完全不耽误事儿,也不需要很多的晾晒空间。

▲说实话,每次收拾烘干机的时候清理这堆毛团都超级治愈啊,因为所有针织物上基本都没有了毛絮,很清爽。
2、洗碗机
好多人买了洗碗机就只是洗碗而已,其实洗碗机可以洗家里的任何可以放在洗碗机里面洗的东西,比如各种调料瓶等,也可以洗油烟机的盒子、罩子、花瓶等。

▲清洗油烟机大概是脏累差家务排行榜第一吧,如果擦玻璃还能考虑自己动手的话,大概清洗油烟机肯定不愿意自己动手的。

▲其实清洗油烟机中最难以下手的部分就是清洗这些组件,以前雇人清洗的时候我也观察过流程,居然都是用烧碱来清洗,我是下不去手的。

▲而现在你只要简单处理一下厚重的油污,然后扔到洗碗机里面就ok了。

▲你看,洗碗机洗后的油烟机还不错吧?烧碱?省省吧!
3、花王厨房清洁剂
当然,配件可以用洗碗机清洗,但是油烟机本身还是要用清洁剂来清理的。不光油烟机本身,包括燃气灶、台面等,用过几个月后都是油腻腻的,当然很多人会建议每次做完饭就顺手清洁,问题是有多少人能顺手做清洁啊?那你顺手洗了碗呗,顺手擦了地呗,顺手擦玻璃么?所以更多的人还是积攒许久一起清理啊。

▲对于清洁剂,我只推两个国家的,日本和德国,真的满满都是黑科技。而日本系列产品中,花王绝对是性价比产品,几乎没有不好用的,从洗发水沐浴露,到清洁剂日用产品,基本拳拳到肉,都能对你的产品需求痛点一击即中。

▲这款花王清洁剂系列中,用的最多的就是这款厨房清洁剂,不光我自己回购无数遍,甚至安利到身边的人几乎人手一瓶了。
▲难能可贵的是对付中式餐饮这种重油污,居然效果非常不错,一喷二溶三擦即可。
▲可以对比一下清洁效果,无需多用力,也不用多长时间,轻轻松松就把油烟机或者厨房台面墙壁的油污清理干净了。
4、氧净多功能清洁剂
在遇到氧净之前,我也用过很多国内国外的清洁剂,但是能让我真正的喔噢的,却只有它,所以好好住的住友们,也由衷的从心底赞叹着:氧净大法好!

▲氧净有厨房餐具系列,也有多功能的,更有专门针对衣物的。

▲很多比较顽固的油污,虽然洗碗机可以清洗,但是很难除去干净,这时候可以先用氧净浸泡。

▲浸泡一段时间后,油污软化,无论是手洗还是洗碗机,都可以轻易的将本来已经准备扔掉的器具又挽救回来了。

▲总不见得每一次大扫除,家里的物品就扔一批吧?所以如果能好好的清洁干净肯定还是更喜欢用这些已经用惯的老物件啊。
总结
很多人、很多家庭,每当提起家务的时候,都不会百分之百的开心,毕竟谁也不愿意动手啊,有视做家务为乐趣的人,请介绍给我!!!我能让他乐哭了!
但是,就算不喜欢,也要做啊,这就是身为一个成年人最不得已的痛苦啊,不想却又不得不。所以,所有能让做家务、大扫除变得轻松一点的好物我都愿意尝试一下。推荐这些不为别的,还不是为了家庭和睦、夫妻融洽么?毕竟,构建一个文明和谐的社会,是每一个公民应尽的义务!